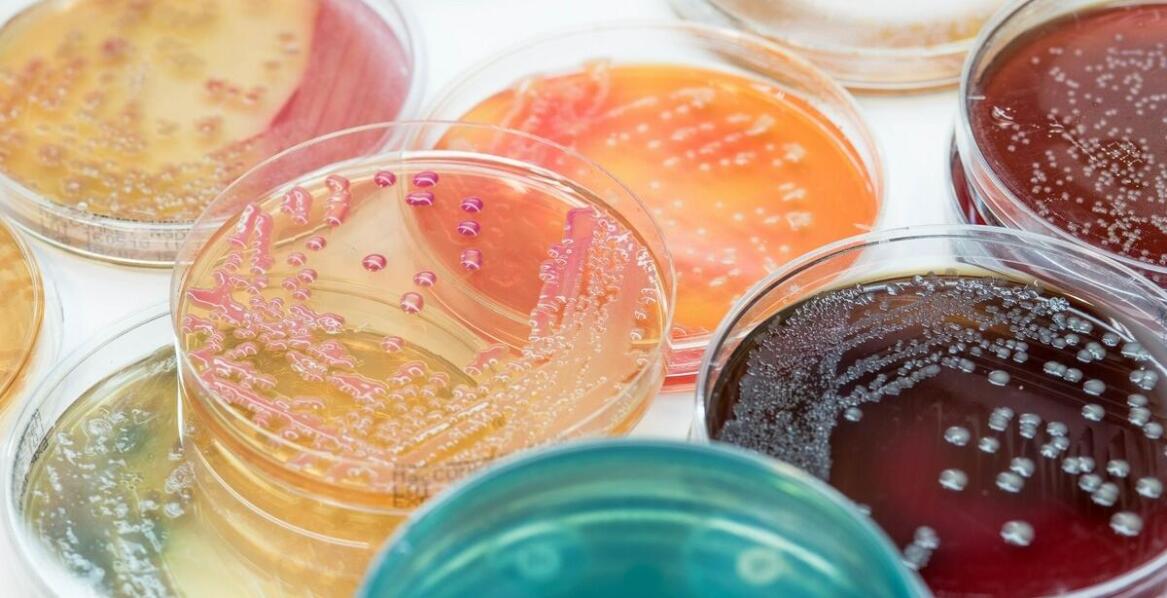
Why are plastic petri dishes preferred in biological laboratories?

How to Choose a Company for Kitchen Renovation?
Choosing the right company for a kitchen renovation is crucial for the project's success. The proper contractor will ensure high-quality work, timeliness, and professionalism, which translates into satisfaction with the final results. Therefore, we suggest how to make a good choice!Read more: H